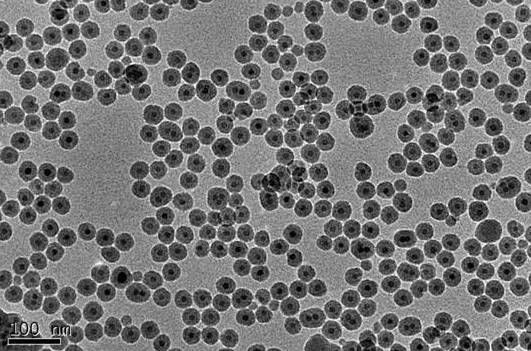
油溶性上转换纳米颗粒 Oil dispersible upconverting nanoparticles

基本信息
产品名称 油溶性上转换纳米颗粒
英文名称 Oil dispersible upconverting nanoparticles
别名 Oil dispersible UCNs
英文别名 Oil dispersible UCNs
规格或纯度 发光波长:365/475 nm,粒径:25nm
运输条件 冰袋运输
一般描述
此系列产品为油溶性上转换纳米颗粒,材料组成为NaYREF4 (RE:Yb, Er, Tm, Gd, Mn, Lu),激发波长为975 nm。敏化离子为Yb3+,激活离子为Er3+或Tm3+。通过调节各离子掺杂浓度,产品在特定波长的发光已得到优化。产品粒径均一,发光量子效率高,光稳定性好。
This series of products contains oil dispersible NaYREF4 (RE:Yb, Er, Tm, Gd, Mn, Lu) UCNs with optimal excitation wavelength at 975 nm. The sensitizer is Yb3+, and the activator is Er3+ or Tm3+. The doping concentrations are optimized, leading to strong upconverted emissions at specific wavelengths. The UCNs are of high quantum efficiency and very photostable.
相关产品:
定制各种上转换纳米颗粒
油溶性核壳结构上转换纳米颗粒
无表面基团水溶性上转换纳米颗粒
氨基修饰上转换纳米颗粒
羧基修饰上转换纳米颗粒
叠氮修饰上转换纳米颗粒
PEG包裹上转化纳米颗粒
PEG-NH2修饰上转换纳米颗粒
PEG-COOH修饰上转换纳米颗粒
DSPE-PEG修饰上转换纳米颗粒
MAL-PEG修饰上转换纳米颗粒
聚丙烯酸修饰上转换纳米颗粒




齐岳微信公众号
官方微信
库存查询